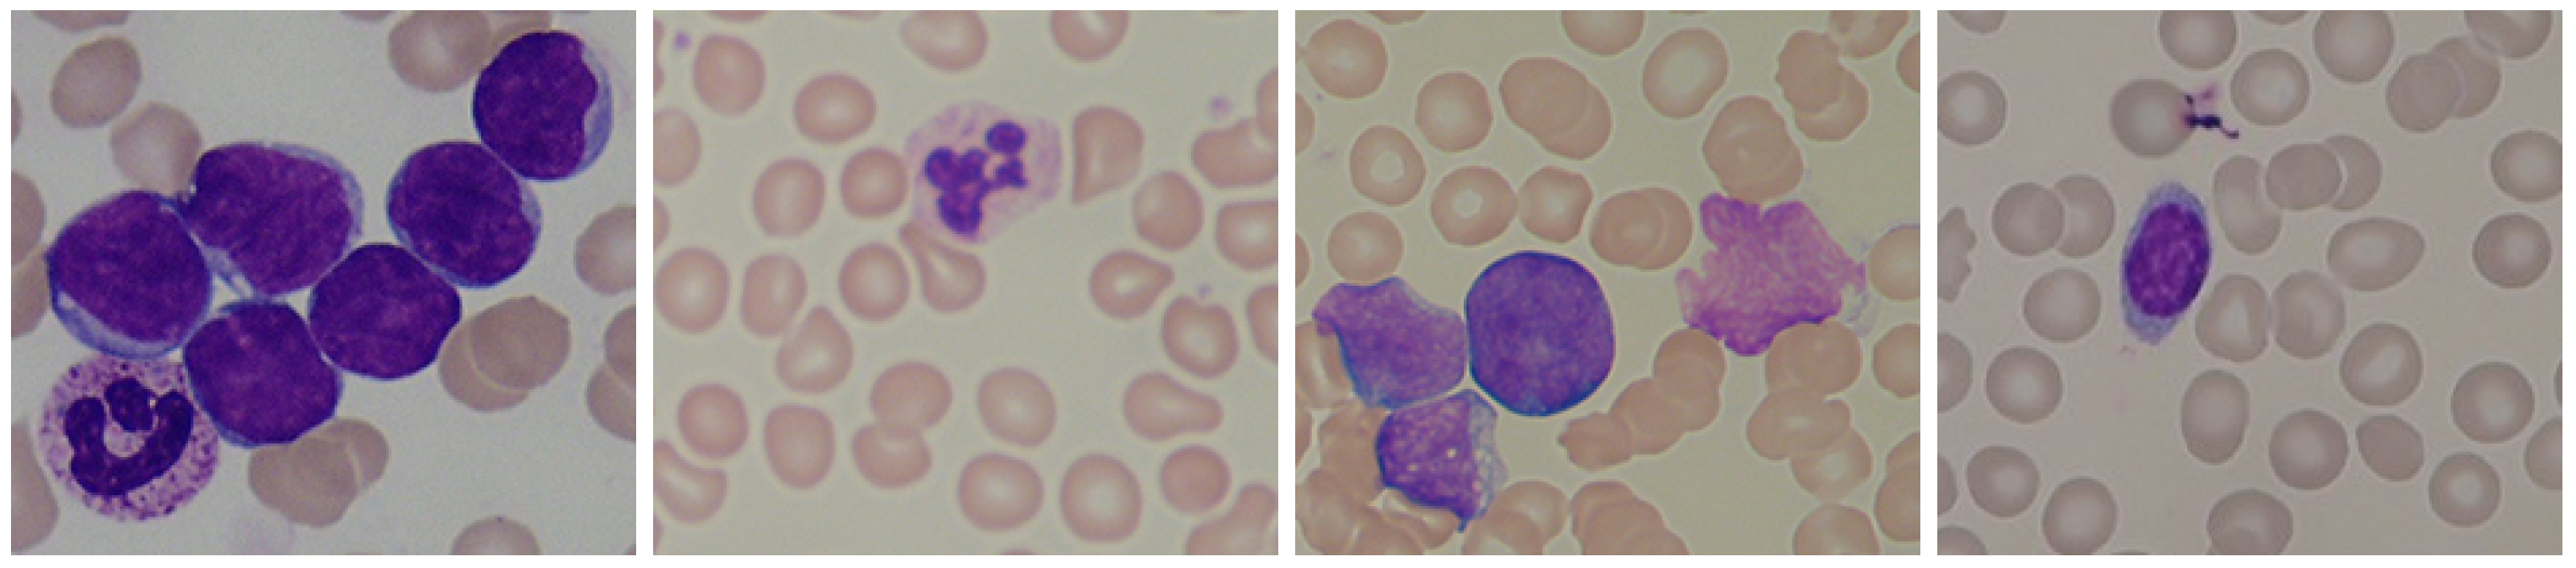

Experience the clarity of blob detection and deep learning for leukemic blood image analysis with our curated collection of vast arrays of images. showcasing the simplicity of picture, photo, and photograph. ideal for clean and simple aesthetics. Browse our premium blob detection and deep learning for leukemic blood image analysis gallery featuring professionally curated photographs. Suitable for various applications including web design, social media, personal projects, and digital content creation All blob detection and deep learning for leukemic blood image analysis images are available in high resolution with professional-grade quality, optimized for both digital and print applications, and include comprehensive metadata for easy organization and usage. Explore the versatility of our blob detection and deep learning for leukemic blood image analysis collection for various creative and professional projects. Regular updates keep the blob detection and deep learning for leukemic blood image analysis collection current with contemporary trends and styles. Our blob detection and deep learning for leukemic blood image analysis database continuously expands with fresh, relevant content from skilled photographers. Diverse style options within the blob detection and deep learning for leukemic blood image analysis collection suit various aesthetic preferences. Reliable customer support ensures smooth experience throughout the blob detection and deep learning for leukemic blood image analysis selection process.

![[논문 리뷰] Detection and Classification of Acute Lymphoblastic Leukemia ...](https://moonlight-paper-snapshot.s3.ap-northeast-2.amazonaws.com/arxiv/detection-and-classification-of-acute-lymphoblastic-leukemia-utilizing-deep-transfer-learning-1.png)

